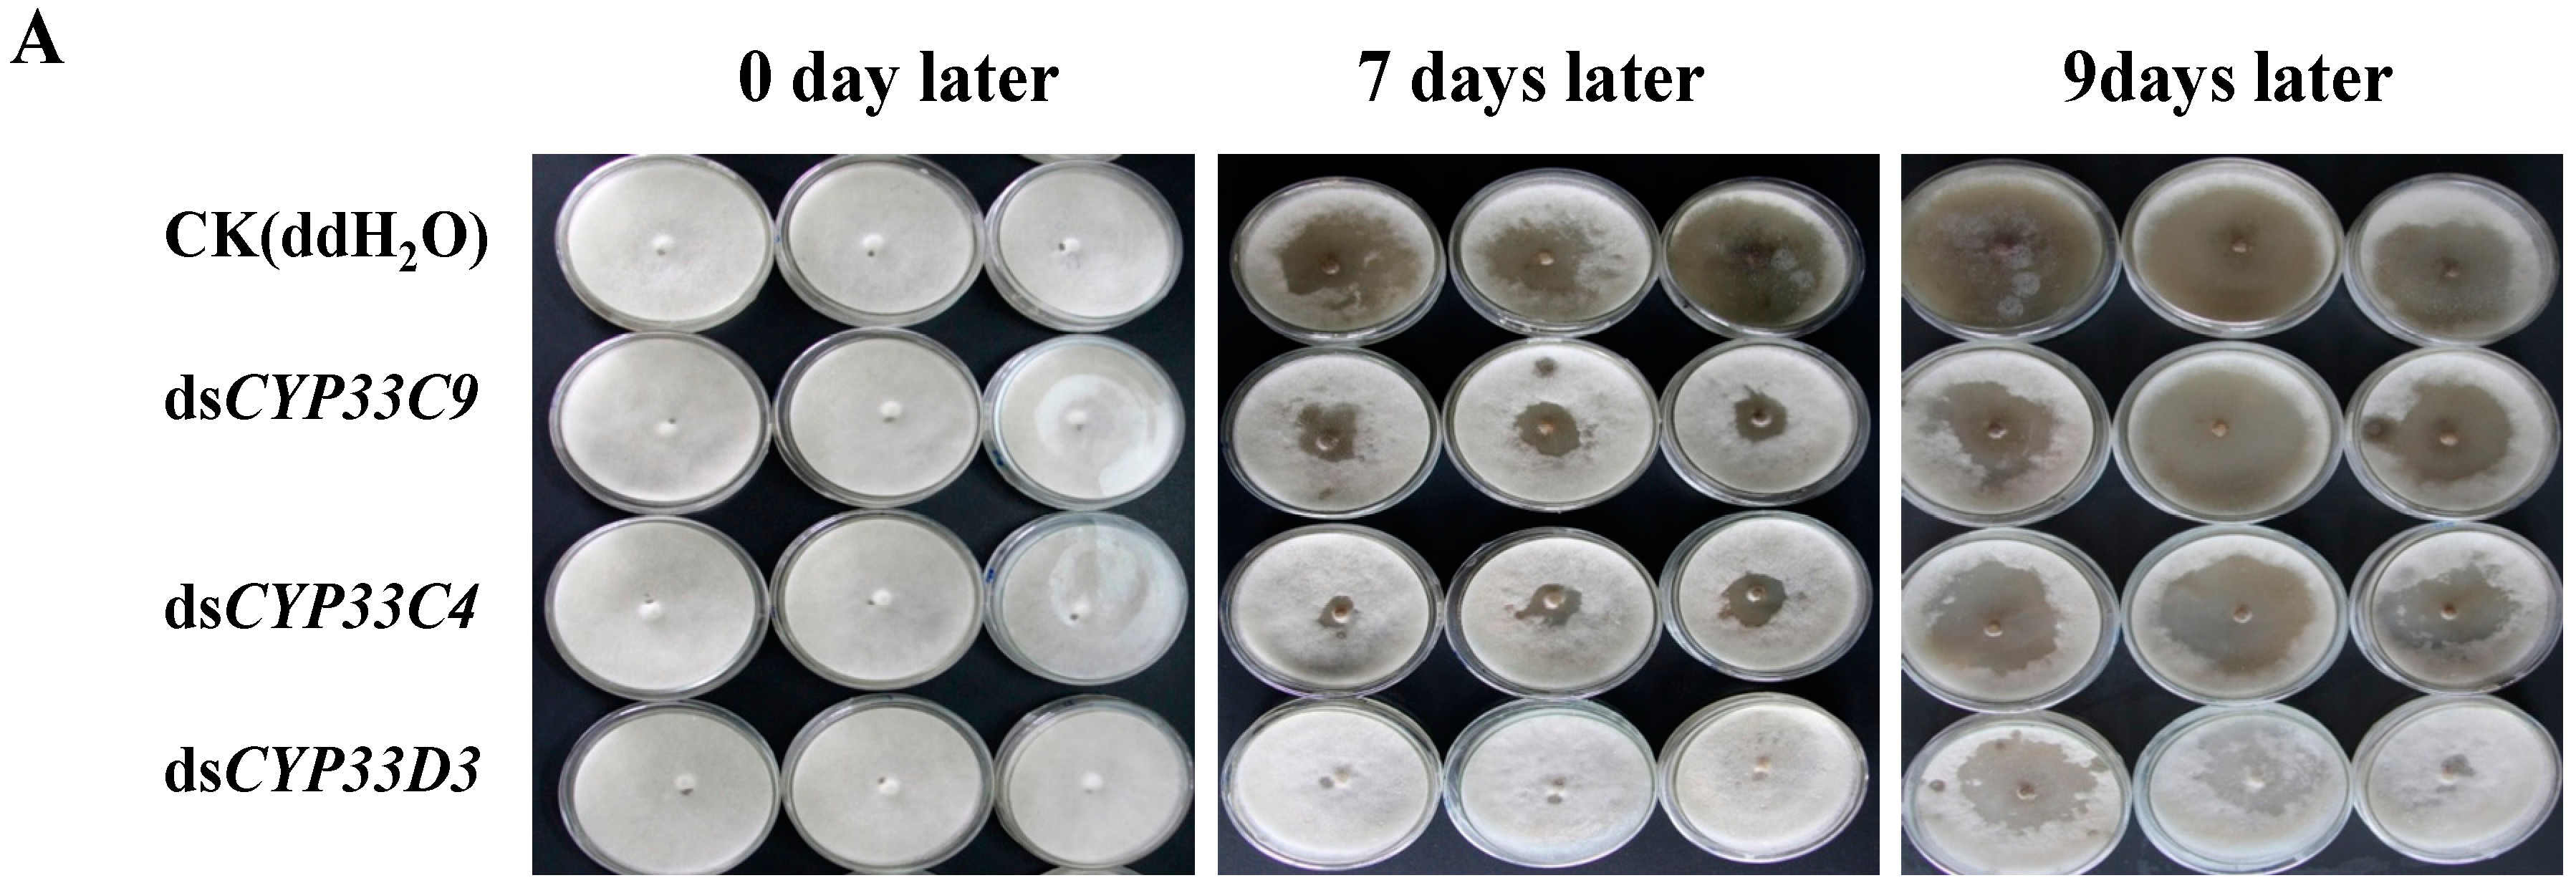
Ijms 16 05216 g005a 1024

Molecular Characterization and Functional Analysis of Three Pathogenesis-Related Cytochrome P450 Genes from Bursaphelenchus xylophilus (Tylenchida: Aphelenchoidoidea)
Abstract
:1. Introduction
2. Results and Discussion
2.1. Cloning and Sequence Analysis of Three Cytochrome P450 Genes from B. xylophilus


2.2. Alignment of the Three Predicted Amino Acid Sequences


2.3. Characteristics of the Three Predicted Proteins
2.4. Detection of RNAi Efficiency
2.5. Vitality and Dispersal Ability of B. xylophilus after RNAi


| Treatments | Detected Time (h) | Number of Nematodes |
|---|---|---|
| ddH2O | 12 | 8.3 ± 2.5 |
| dsCYP33D3 | 24 | 2.7 ± 1.1 |
| dsCYP33C4 | 96 | 2.3 ± 1.5 |
| dsCYP33C9 | 144 | 3.7 ± 1.5 |
2.6. Reproduction and Pathogenicity of B. xylophilus after RNAi

2.7. Susceptibility of B. xylophilus to Pesticides after RNAi
2.8. Discussion


3. Experimental Section
3.1. Materials
3.2. Collection of B. xylophilus
3.3. RNA Extraction of B. xylophilus
3.4. Full-Length cDNA Cloning of P450s from B. xylophilus
3.5. Bioinformatic Analysis
| Name of Primer | Sequence (5'-3') |
|---|---|
| cDNA Cloning of three cytochrome P450 genes | |
| 3'RACE outer primer | TACCGTCGTTCCACTAGTGATTT |
| GSP1 | TTCGCCCGAACAAGCGTATA |
| GSP2 | AATGTTGGACTGCTGGATGA |
| 5'RACE outer primer | CATGGCTACATGCTGACAGCCTA |
| GSP3 | TGTGATAGCGATGAGTGA |
| 5'RACE inner primer | CGCGGATCCACAGCCTACTGATGATCAGTCGATG |
| GSP4 | TTGAAAGGCTCGGGAAAT |
| M13F(−47) | CGCCAGGGTTTTCCCAGTCACGAC |
| M13R(−48) | AGCGGATAACAATTTCACACAGGA |
| Preparation of template DNA for dsRNA | |
| BxC4T7F | TAATACGACTCACTATAGGGTTGGGAGTGAACGGATGA |
| BxC4R | GATCGCATGACTTCTTGTA |
| BxC4F | TTGGGAGTGAACGGATGA |
| BxC4T7R | TAATACGACTCACTATAGGGGATCGCATGACTTCTTGTA |
| BxC9T7F | TAATACGACTCACTATAGGGGCAGCTATGATTGATGGT |
| BxC9R | CAATGAGAAGTAATGTGGC |
| BxC9F | GCAGCTATGATTGATGGT |
| BxC9T7R | TAATACGACTCACTATAGGGCAATGAGAAGTAATGTGGC |
| BxD3T7F | TAATACGACTCACTATAGGGGCCCGAGATTTACCAAGA |
| BxD3R | AACGCATCAATCAGACACTT |
| BxD3F | GCCCGAGATTTACCAAGA |
| BxD3T7R | TAATACGACTCACTATAGGGAACGCATCAATCAGACACTT |
| Real time PCR | |
| qC9F1 | GCGGTTTGCCATGAGACT |
| qC9R1 | AAACGGGTGGGATCGAAT |
| qC4F1 | AAGATCGACCGCCAGATG |
| qC4R1 | CACCTCCAGCTGCATCCT |
| qD3F1 | CTGATGGGGCAAAGTTGG |
| qD3R1 | GCGGGTCCGAAATGTAGA |
| Actin F | GCAACACGGAGTTCGTTGTAGA |
| Actin R | GTATCGTCACCAACTGGGATGA |
3.6. RNA Interference (RNAi)
3.7. Quantitative Real-Time RT-PCR
3.8. Analysis of Vitality and Dispersal Ability of B. xylophilus after RNAi
3.9. Analysis of Reproduction and Pathogenicity of B. xylophilus after RNAi
3.10. Analysis of Susceptibility of B. xylophilus to Pesticides after RNAi
3.11. Statistical Analysis
Acknowledgments
Author Contributions
Conflicts of Interest
References
- Mamiya, Y. Pathology of the pine wilt disease caused by Bursaphelenchus xylophilus. Annu. Rev. Phytopathol. 1983, 21, 201–220. [Google Scholar] [CrossRef]
- Mota, M.M.; Braasch, H.; Bravo, M.A.; Penas, A.C.; Burgermeister, W.; Metge, K.; Sousa, E. First report of Bursaphelenchus xylophilus in Portugal and in Europe. Nematology 1999, 1, 727–734. [Google Scholar] [CrossRef]
- Penas, A.C.; Correia, P.; Bravo, M.A.; Mota, M.; Tenreiro, R. Species of Bursaphelenchus Fuchs, 1937 (Nematoda: Parasitaphelenchidae) associated with maritime pine in Portugal. Nematology 2004, 6, 437–453. [Google Scholar] [CrossRef]
- Fonseca, L.; Cardoso, J.M.S.; Lopes, A.; Pestana, M.; Abreu, F.; Nunes, N.; Mota, M.; Abrantes, I. The pinewood nematode, Bursaphelenchus xylophilus, in Madeira Island. Helminthologia 2012, 49, 96–103. [Google Scholar] [CrossRef]
- Wingfield, M.J.; Blanchette, R.A. The pine-wood nematode, Bursaphelenchus xylophilus, in Minnesota and Wisconsin: Insect associates and transmission studies. Can. J. For. Res. 1983, 13, 1068–1076. [Google Scholar] [CrossRef]
- Ceng, H.R.; Lin, M.S.; Ni, W.Q.; Fang, Z.D. First report of pine wilt disease from Pinus thunbergii Parl in Nanjing. For. Pest Dis. 1983, 4, 1–5. [Google Scholar]
- Jones, J.T.; Moens, M.; Mota, M.; Li, H.; Kikuchi, T. Bursaphelenchus xylophilus: Opportunities in comparative genomics and molecular host-parasite interactions. Mol. Plant Pathol. 2008, 9, 357–368. [Google Scholar] [CrossRef] [PubMed]
- Kikuchi, T.; Jones, J.T.; Aikawa, T.; Kosaka, H.; Ogura, N. A family of glycosyl hydrolase family 45 cellulases from the pine wood nematode Bursaphelenchus xylophilus. FEBS Lett. 2004, 572, 201–205. [Google Scholar] [CrossRef] [PubMed]
- Kikuchi, T.; Shibuya, H.; Aikawa, T.; Jones, J.T. Cloning and characterization of pectatelyases expressed in the esophageal gland of the pine wood nematode Bursaphelenchus xylophilus. Mol. Plant Microbe Interact. 2006, 19, 280–287. [Google Scholar] [CrossRef] [PubMed]
- Coon, M.J.; Vaz, A.D.; Bestervelt, L.L. Cytochromes P450 2: Peroxidative reactions of diversozymes. FASEB J. 1996, 10, 428–434. [Google Scholar] [PubMed]
- Werck, R.D.; Feyereisen, R. Cytochromes P450: A success story. Genome Biol. 2002, 6, 1–9. [Google Scholar]
- Li, X.; Schuler, M.A.; Berenbaum, M.R. Molecular mechanisms of metabolic resistance to synthetic and natural xenobiotics. Annu. Rev. Entomol. 2007, 52, 231–253. [Google Scholar] [CrossRef] [PubMed]
- Schuler, M.A. P450s in plant-insect interactions. Biochim. Biophys. Acta 2011, 1814, 36–45. [Google Scholar] [CrossRef] [PubMed]
- Nebert, D.W.; Russell, D.W. Clinical importance of the cytochromes P450. Lancet 2002, 360, 1155–1165. [Google Scholar] [CrossRef] [PubMed]
- Yue, L.; Yang, Y.; Wu, S.; Wu, Y. Cloning and mRNA expression levels of cytochrome P450 genes CYP6AE12 and CYP9A18 in the cotton bollworm, Helicover armigera (Hȕbner). Acta Entomol. Sin. 2007, 50, 234–240. [Google Scholar]
- Yu, R.R. Molecular Characterization and Functional Analysis of Three Cytochrome P450 Genes from Locusta migratoria. Master Thesis, Shanxi University, Taiyuan, China, 2012. [Google Scholar]
- Xu, Y.Q. Molecular Cloning, Sequence Analysis and Expression of Cytochrome P450 Gene in Tribolium castaneum (Herbst). Master Thesis, Southwest University, Chongqing, China, 2009. [Google Scholar]
- Qiu, X.; Wu, X.; Huang, L.; Tian, M.; Ye, J. Specifically expressed genes of the nematode Bursaphelenchus xylophilus involved with early interactions with pine trees. PLoS One 2013, 8, e78063. [Google Scholar] [CrossRef] [PubMed]
- Yang, B.J. Advance in research of pathogenetic mechanism of pine wood nematode. For. Pest Dis. 2002, 1, 27–31. [Google Scholar]
- Dropkin, V.H.; Foudin, A.; Kondo, E.; Linit, M.; Smith, M.; Robbins, K. Pine wood nematode: A threat to U.S. forest. Plant Dis. 1981, 65, 1022–1027. [Google Scholar] [CrossRef]
- Taiz, L. Plant cell expansion: Regulation of cell wall mechanical properties. Annu. Rev. Plant Physiol. 1984, 35, 585–657. [Google Scholar] [CrossRef]
- Qin, L.; Kudla, U.; Roze, E.H.; Goverse, A.; Popeijus, H.; Nieuwland, J.; Overmars, H.; Jones, J.T.; Schots, A.; Smant, G.; et al. Plant degradation: A nematode expansin acting on plants. Nature 2004, 427, 30–30. [Google Scholar]
- Lin, S.F.; Guo, L.; Jian, H.; Zhang, G.Z. Construction of specific cDNA library and cloning of expansin gene from the ante-rior end of Bursaphelenchus xylophilus. Acta Phytopathol. Sin. 2008, 3, 283–291. [Google Scholar]
- Kang, J.S.; Koh, Y.H.; Moon, Y.S.; Lee, S.H. Molecular properties of a venom allergen-like protein suggest a parasitic function in the pine wood nematode Bursaphelenchus xylophilus. Int. J. Parasitol. 2012, 42, 63–70. [Google Scholar] [CrossRef] [PubMed]
- Sorensen, J.G.; Kristensen, T.N.; Loeschcke, V. The evolutionary and ecological role of heat shock proteins. Ecol. Lett. 2003, 6, 1025–1037. [Google Scholar] [CrossRef]
- Dai, S.M.; Cheng, X.Y.; Xiao, Q.M.; Xie, B.Y. Cloning and prokaryotic expression of Hsp70 from pine wood nematode (Bursaphelenchus xylophilus). Acta Phytopathol. Sin. 2007, 37, 512–519. [Google Scholar]
- Sun, Y.; MacRae, T.H. The small heat shock proteins and their role in human disease. FEBS J. 2005, 272, 2613–2627. [Google Scholar] [CrossRef] [PubMed]
- Liu, L.H.; Wang, F.; Wang, B.Y.; Ma, L; Yang, Y.; Cui, W.C. Gene cloning and protein structure implications of a Bx-sHSP16A from Bursaphelenchus xylophilus. Chin. Agric. Sci. Bull. 2013, 29, 40–45. [Google Scholar]
- Terriere, L.C. Enzyme induction, gene amplification and insect resistance to insecticides. In Pest Resistance to Pesticides; Springer: New York, NY, USA, 1983; pp. 265–297. [Google Scholar]
- Batar, M.; Schalk, M.A.; Pierrel, A.; Zimmerlin, F.D.; Werck, R.D. Regulation of the cinnamate 4-hydrolase (CYP73A1) in Jersusalem artichoke tubers in reponse to wounding and chemical treatments. Plant Physiol. 1997, 113, 951–959. [Google Scholar] [PubMed]
- Terriere, L.C. Induction of detoxication enzymes in insects. Annu. Rev. Entomol. 1984, 29, 71–88. [Google Scholar] [CrossRef] [PubMed]
- Gonzalez, F.J.; Nebert, D.W. Evolution of the P450 gene superfamily: Animal-plant “warfare”, molecular drive and human genetic differences in drug oxidation. Trends Genet. 1990, 6, 182–186. [Google Scholar] [CrossRef] [PubMed]
- Nelson, D.R.; Kamataki, T.; Waxman, D.J.; Guengerich, F.P.; Estabrook, R.W.; Feyereisen, R.; Gonzalez, F.J.; Coon, M.J.; Gunsalus, I.C.; Gotoh, O.; et al. The P450 superfamily: Update on new sequences, gene mapping, accession numbers, early trivial names of enzymes, and nomenclature. DNA Cell Biol. 1993, 12, 1–51. [Google Scholar]
- Santos, C.S.; Pinheiro, M.; Silva, A.I.; Egas, C.; Vasconcelos, M.W. Searching for resistance genes to Bursaphelenchus xylophilus using high throughput screening. BMC Genomics 2012, 13. [Google Scholar] [CrossRef] [PubMed]
- Fire, A.; Xu, S.; Montgomery, M.K.; Kostas, S.A.; Driver, S.E.; Mello, C.C. Potent and specific genetic interference by double-stranded RNA in Caenorhabditis elegans. Nature 1998, 391, 806–811. [Google Scholar] [CrossRef] [PubMed]
- Aravin, A.A.; Naumova, N.M.; Tulin, A.V.; Vagin, V.V.; Rozovsky, Y.M.; Gvozdev, V.A. Double-stranded RNA-mediated silencing of genomic tandem repeats and transposable elements in the D. melanogaster germline. Curr. Biol. 2001, 11, 1017–1027. [Google Scholar] [CrossRef]
- Wesley, S.V.; Helliwell, C.A.; Smith, N.A.; Wang, M.; Rouse, D.T.; Liu, Q.; Gooding, P.S.; Singh, S.P.; Abbott, D.; Stoutjesdijk, P.A.; et al. Construct design for efficient, effective and high-throughput gene silencing in plants. Plant J. 2001, 27, 581–590. [Google Scholar]
- Sugimoto, A. High-throughput RNAi in Caenorhabditis elegans: Genome-wide screens and functional genomics. Differentiation 2004, 72, 81–91. [Google Scholar] [CrossRef] [PubMed]
- Urwin, P.; Lilley, C.; Atkinson, H. Ingestion of Double-stranded RNA by pre parasitic juvenile cyst nematodes leads to RNA interference. Mol. Plant Microbe Interact. 2002, 15, 747–752. [Google Scholar] [CrossRef] [PubMed]
- Tsalik, E.L.; Hobert, O. Functional mapping of neurons that control locomotory behavior in Caenorhabditis elegans. J. Neurobiol. 2003, 56, 178–179. [Google Scholar] [CrossRef] [PubMed]
- Oku, H.; Shiraishi, T.; Chikamatsu, K. Active defense as a mechanism of resistance in pine against pine wilt disease. Ann. Phytopathol. Soc. JPN 1989, 55, 603–608. [Google Scholar] [CrossRef]
- Zhu, L.H.; Ye, J.R.; Negi, S.; Xu, X.L.; Wang, Z.L.; Ji, J.Y. Pathogenicity of aseptic Bursaphelenchus xylophilus. PLoS One 2012, 7, e38095. [Google Scholar] [CrossRef] [PubMed]
- Lai, Y.X.; CHI, S.Y.; Wang, Y.H.; Zhang, Y.F.; Han, Z.M. Pesticide toxicity and selection for the pine wood nematode. J. Zhejiang Agric. For. Univ. 2011, 28, 479–485. [Google Scholar]
© 2015 by the authors; licensee MDPI, Basel, Switzerland. This article is an open access article distributed under the terms and conditions of the Creative Commons Attribution license (http://creativecommons.org/licenses/by/4.0/).
Share and Cite
Xu, X.-L.; Wu, X.-Q.; Ye, J.-R.; Huang, L. Molecular Characterization and Functional Analysis of Three Pathogenesis-Related Cytochrome P450 Genes from Bursaphelenchus xylophilus (Tylenchida: Aphelenchoidoidea). Int. J. Mol. Sci. 2015, 16, 5216-5234. https://doi.org/10.3390/ijms16035216
Xu X-L, Wu X-Q, Ye J-R, Huang L. Molecular Characterization and Functional Analysis of Three Pathogenesis-Related Cytochrome P450 Genes from Bursaphelenchus xylophilus (Tylenchida: Aphelenchoidoidea). International Journal of Molecular Sciences. 2015; 16(3):5216-5234. https://doi.org/10.3390/ijms16035216
Chicago/Turabian StyleXu, Xiao-Lu, Xiao-Qin Wu, Jian-Ren Ye, and Lin Huang. 2015. "Molecular Characterization and Functional Analysis of Three Pathogenesis-Related Cytochrome P450 Genes from Bursaphelenchus xylophilus (Tylenchida: Aphelenchoidoidea)" International Journal of Molecular Sciences 16, no. 3: 5216-5234. https://doi.org/10.3390/ijms16035216
APA StyleXu, X.-L., Wu, X.-Q., Ye, J.-R., & Huang, L. (2015). Molecular Characterization and Functional Analysis of Three Pathogenesis-Related Cytochrome P450 Genes from Bursaphelenchus xylophilus (Tylenchida: Aphelenchoidoidea). International Journal of Molecular Sciences, 16(3), 5216-5234. https://doi.org/10.3390/ijms16035216
